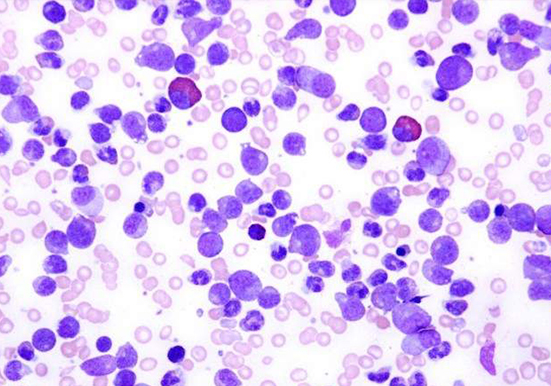

服务详情
以下是关于嗜酸性粒细胞染色的相关内容:
染色方法
瑞氏染色
原理:瑞氏染料由酸性染料伊红(E-)和碱性染料亚甲蓝(M+)组成。既有物理的吸附作用,又有化学的亲和作用。血红蛋白、嗜酸性颗粒为碱性蛋白质,与酸性染料伊红结合,染粉红色;细胞核蛋白、淋巴细胞、嗜碱性粒细胞胞质为酸性,与碱性染料美蓝或天青结合,染紫蓝色或蓝色。
操作步骤:首先采血制成血涂片,干燥后做好标记,将血涂片平置于染色架上,滴加瑞氏染液 Ⅰ 液 3~5 滴,使其迅速盖满血涂片,约 0.5~1min 后,滴加等量或稍多的 Ⅱ 液,轻轻摇动玻片或用吸球吹气,使染液充分混合,5~10min 后用流水冲去染液,待干镜检。
吉姆萨染色
原理:吉姆萨染液由天青、伊红组成,染色原理和结果与瑞氏染色基本相同。
操作步骤:先按瑞氏染色的方法进行采血、推片、干燥、标记,然后用甲醇固定 3~5min,再将血涂片置于用磷酸盐缓冲液(pH6.4~6.8)稀释 10~20 倍的吉姆萨染液中,浸泡 10~30min,最后取出用流水冲洗,待干镜检。
荧光标记染色
原理:使用荧光标记的抗体或染料对细胞进行染色,荧光标记的抗体或染料会特异性地与嗜酸性粒细胞结合,然后在荧光显微镜下观察,嗜酸性粒细胞会呈现出特定的荧光颜色。
操作步骤:一般先将细胞固定在载玻片上,然后加入荧光标记的抗体或染料,孵育一段时间,使抗体或染料与嗜酸性粒细胞充分结合,之后用缓冲液冲洗,去除未结合的荧光物质,最后在荧光显微镜下观察。
伊红 - 亚甲蓝染色
原理:伊红是酸性染料,亚甲蓝是碱性染料,嗜酸性粒细胞中的嗜酸性颗粒具有碱性,可与酸性染料伊红结合,而细胞核等成分可与亚甲蓝结合,从而使嗜酸性粒细胞呈现出深紫色或深蓝色的颗粒。
操作步骤:将血液涂片或骨髓涂片进行固定,然后用伊红 - 亚甲蓝染液进行染色,染色后用流水冲洗,干燥后在显微镜下观察。